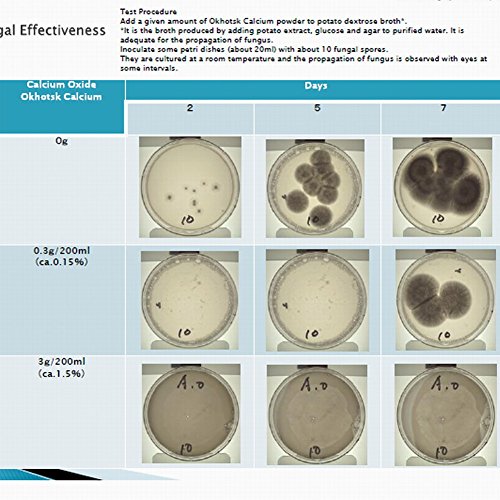

الوصف
- The most effective and safe cleaner for cleaning up pesticides, preservatives, wax, and bacteria on fruits and vegetables.
- It is 100% Natural, and 100% safe, there are not chemical additives or side effects or odor. It is Ionized calcium ( CaO over 95% ) made in Japan, made of natural scallops shell.
- 1kg fruits or vegetables,1 litre water, 1g -1.5g shell powder (about sprinkle 3-4 times), soak 10 minutes.Can find the floating material resulted from removal of various pollutant and harmful bacteria and wax from fruits and vegetables. Pick up the fruits and/or vegetables from the water (purier solution), wash them in the running water and then eat or cook
- It also can be used as Natural Laundry Sanitizer in washer, has sterilization, deodorization, mildew proof effect. proportion is 20 litres water to 1-3g powder cleaner, directly put the shell powder cleaner in wahser
- It may be used as Natural Deodorant in toilet, restroom, shoes and room, use 1 litre water to 1g powder cleaner in sprayer, spray it in home, toilet, and shoes.
No Chemical Additives / No Surfactants / No Preservatives / No Odor 100% Natural Eco Friendly Cleaner and Detergent Natural Cleaner of shell powder is the most effective and safe cleaner for clean up pesticides, preservatives, wax, and bacteria on fruits and vegetables. . It is Ionized calcium ( CaO over 95% ) made in Japan, and made of natural scallops shell by ultra high temperature calcination technology. 1kg fruits or vegetables use 1 litre water, and sprinkle 3-4 times of shell powder, then only soak 10 minutes in water over 99% pesticides and bacteria and germ are cleaned up, you may see floating material on water or water become yellow if there is too much pesticides on fruits or vegetables. It also can be used as Laundry Sanitizer and Deodorant, has sterilization, deodorization, mildew proof effect.